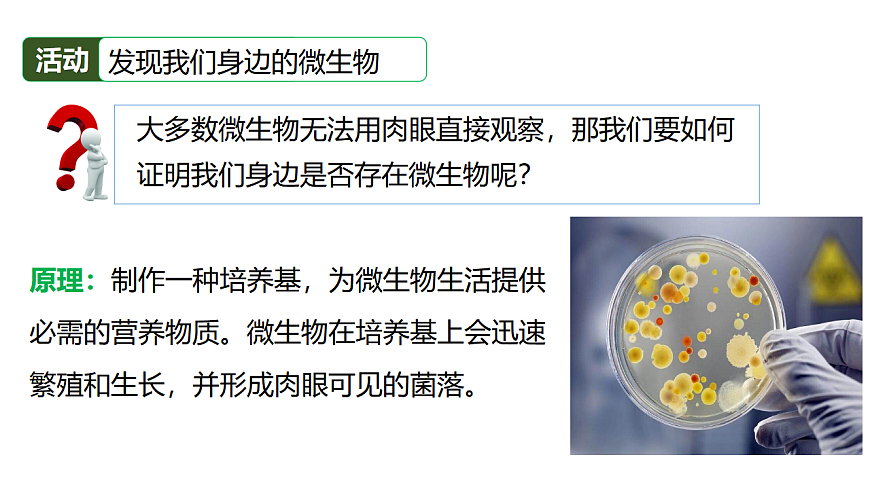
17333486第7页
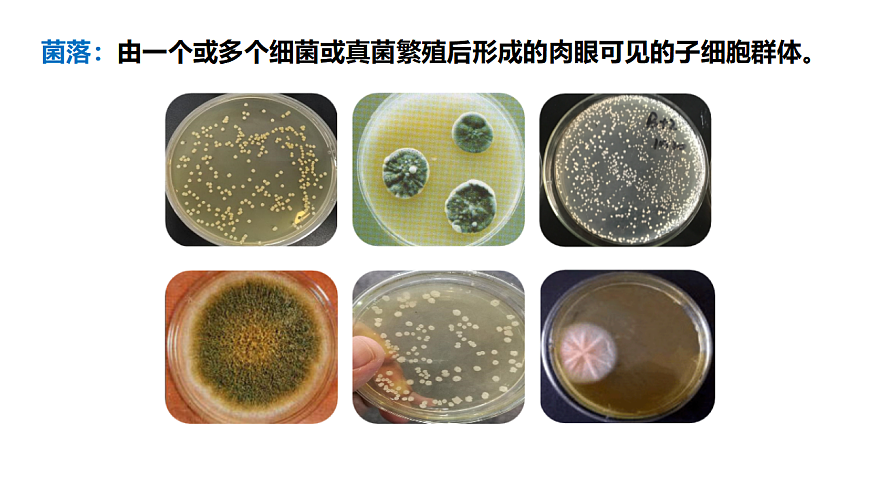
17333486第8页

若您为此资料的原创作者,认为该资料内容侵犯了您的知识产权,请扫码添加我们的相关工作人员,我们尽可能的保护您的合法权益。

1/46

2/46

3/46

4/46

5/46

6/46
7/46
8/46
还剩38页未读,
继续阅读
生物八年级上册(2024)微生物的特点和主要类型课前预习课件ppt
展开
这是一份生物八年级上册(2024)微生物的特点和主要类型课前预习课件ppt,共46页。
相关课件
北师大版(2024)八年级上册(2024)微生物的特点和主要类型教学课件ppt:
这是一份北师大版(2024)八年级上册(2024)微生物的特点和主要类型教学课件ppt,共47页。PPT课件主要包含了肉眼不可见的微生物,什么是微生物,肉眼可见的微生物,微生物的发现,微生物的分布,微生物无处不在,微生物的主要类群,细胞壁,①酵母菌,②霉菌等内容,欢迎下载使用。
初中生物北师大版(2024)八年级上册(2024)微生物与人类的关系说课课件ppt:
这是一份初中生物北师大版(2024)八年级上册(2024)微生物与人类的关系说课课件ppt,共24页。
初中生物北师大版(2024)八年级上册(2024)微生物的特点和主要类型教学演示课件ppt:
这是一份初中生物北师大版(2024)八年级上册(2024)微生物的特点和主要类型教学演示课件ppt,共48页。
相关课件 更多
资料下载及使用帮助
版权申诉
- 1.电子资料成功下载后不支持退换,如发现资料有内容错误问题请联系客服,如若属实,我们会补偿您的损失
- 2.压缩包下载后请先用软件解压,再使用对应软件打开;软件版本较低时请及时更新
- 3.资料下载成功后可在60天以内免费重复下载
版权申诉

 免费领取教师福利
免费领取教师福利















